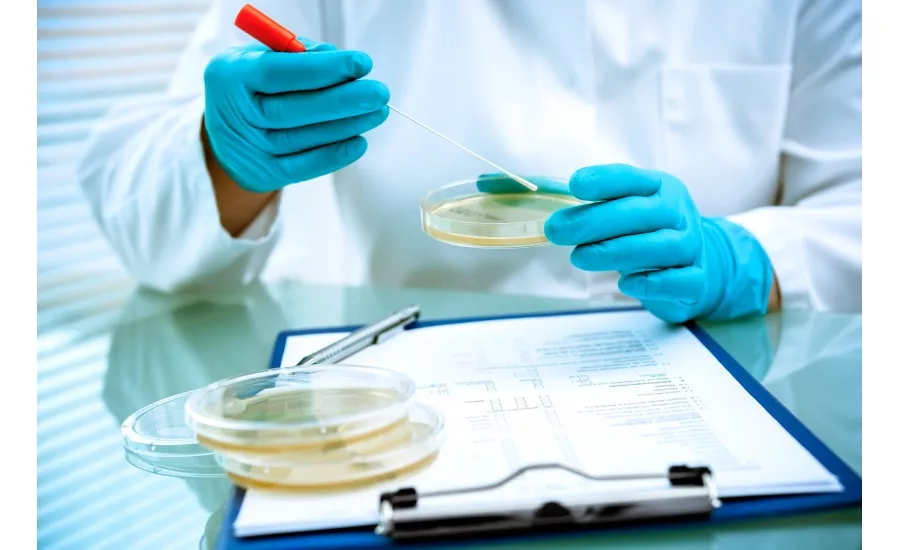
Environmental Monitoring: Stay Ahead of Food Safety Risks with Continuous Improvements

Environmental monitoring: stay ahead of food safety risks with continuous improvements
Food safety does not end with the creation of a documented plan. It must be an ongoing effort, especially in processing facilities producing ready-to-eat (RTE) products, where product contamination may lead to public health risks, costly recalls and reputation damage.
Having a facility that meets or exceeds industry accepted principles of sanitary design, coupled with effective and verifiable sanitation processes is the foundation. But having a comprehensive environmental monitoring program (EMP) is an essential component of an effective food safety system. In many industries a continuous improvement model is viewed as a way to make operations more efficient and productive. In food safety, environmental monitoring helps drive continuous improvement in cleaning and sanitation practices to detect and mitigate food safety risks. One of the most notable being Listeria contamination.
Essentials of an Environmental Monitoring Program
An effective EMP allows RTE food processors to accomplish several important goals:
- Verify the effectiveness of your cleaning and sanitation processes
- Allow for incremental adjustments to improve best practices
- Serve as an early warning system for contamination risks
- Help processors develop the facility’s microbiological map
- Achieve FSMA compliance (EMPs are a requirement of the FDA’s Food Safety Modernization Act)
The FDA states that an EMP is “more effective than product testing alone,” because it promotes increased awareness and knowledge of environmental conditions that present food safety risks.
At its core, an EMP incorporates a planned program of random microbiological swab samples collected at designated areas around the plant. These tests may confirm that your food safety plan is working as intended. Or, they could indicate places where cleaning and sanitation can be improved upon.
If test results are positive for problematic bacteria, such as Listeria, the sanitation crew must act to address the issue. You need to answer three questions: Has my product been contaminated, why has the positive result occurred, and what should be changed to reduce the risk of contamination?
As with the overall food safety plan, your plant’s EMP should be well documented, indicating how and where samples are taken as well as testing frequency. Most importantly, a documented EMP should define actions the sanitation crew takes if there is a positive result.
The Next Step: A “Seek and Destroy” Strategy
For RTE food processors looking to take environmental monitoring to the next level, a “seek and destroy” approach can be implemented. This proactive mentality involves additional swabbing and testing of areas outside the documented plan, which you suspect are problematic.
Looking for quick answers on food safety topics?
Try Ask FSM, our new smart AI search tool.
Ask FSM →
Most organizations will be familiar with the concept of zoning in a food processing facility. Zone 1 includes food contact surfaces in primary processing or any surface that material could drip, drop or slide onto a food contact surface from. Zone 2 includes non-food contact surfaces near Zone 1. Zone 3 is non-product areas and equipment adjacent to Zone 2, and Zone 4 covers the more remote areas, such as loading docks and employee restrooms.
Focusing additional environmental monitoring on Zones 2 and 3 makes your program stronger, especially if you are thinking strategically about how product contamination may occur.
While larger processors may have EMPs in place, small- to mid-sized operations are still working to develop their programs and make full use of the information obtained from testing. But, this is the key to effective environmental monitoring, collecting and analyzing the data and using the results. If results indicate opportunities for improvement, but it’s unclear what you should do next, find food safety experts who can guide you towards solutions that protect your brand and the food chain.







